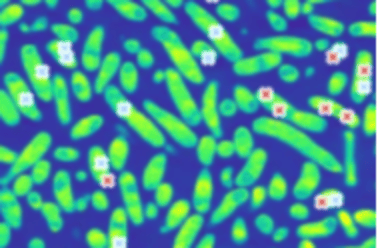

New study uncovers mechanisms of bacterial dormancy involving protein aggregation
Researchers revealed a mechanism involving protein aggregation that allows bacteria to enter a dormant state
Leuven, 28 January 2025 – Researchers at the VIB-KU Leuven Center for Microbiology and the VIB-KU Leuven Center for Brain & Disease Research revealed a mechanism involving protein aggregation that allows bacteria to enter a dormant state, a phenomenon that is associated with the persistence of infections and the challenge of antibiotic resistance. Their work appears in Nature Communications.
Sleeping bacteria
As antibiotic resistance continues to escalate globally, understanding how bacteria can evade treatment is more critical than ever. Some bacteria can enter dormant states, during which they are not susceptible to antibiotics. Dormant bacteria, including persister cells and viable but non-culturable cells (VBNCs), survive antibiotic exposure and can later ‘reactivate’, leading to recurrent infections. One of the bacteria that can pull off this trick is Escherichia coli, commonly associated with various infections in humans.
Led by Prof. Jan Michiels (VIB-KU Leuven) and Prof. Liselot Dewachter (UCLouvain), the researchers, alongside colleagues from the Switch lab (VIB-KU Leuven), explored the relationship between protein aggregation and bacterial dormancy.
“We found,” says Prof. Dewachter, “that when we subject bacteria to stress, proteins involved in their energy metabolism start to condensate, meaning that they start to clump together in gel-like droplets. Over time, these droplets solidify, which may protect the bacteria and help them survive. Interestingly, while protein aggregation has previously been associated with neurodegenerative diseases like Alzheimer’s, our findings reveal a surprising positive side to protein aggregation. Our work shows that protein aggregates are not necessarily detrimental, but can actually benefit cells by promoting their survival in stressful environments, such as during antibiotic treatment.”
Different states
The authors show that the two processes – bacterial dormancy and protein condensation – are tightly connected. By aggregating several proteins involved in metabolism, the condensation process effectively shuts down bacterial energy production.
Dr. Celien Bollen, first author of the study, explains, “We found that the timing of protein condensation and dormancy is closely linked across different strains of E. coli. This suggests that the process is conserved, potentially offering a therapeutic target for future treatments.”
Importantly, the scientists found that dormant E. coli cells can recover and regrow by dissolving these protein aggregates. The chaperone protein DnaK can literally pull proteins out of the condensates and reactivate bacterial metabolism.

“There are different states of dormancy,” explains Prof. Jan Michiels. “The bacteria first enter a persister state, where metabolism slows down and energy-related proteins start to form condensates, but they still show some activity, akin to a sleeping state. However, if the stress lasts, the protein droplets solidify and the bacteria transition into the VBNC state. In this state, metabolism drops even further, and it takes the bacteria longer to become active again, resembling more of a coma.”
“By disrupting the processes that lead to dormancy,” Bollen adds, “we may be able to improve the effectiveness of existing antibiotics and reduce the incidence of persistent infections. This is particularly relevant in the context of rising antibiotic resistance, which is a significant threat to public health.”

Publication
Composition and liquid-to-solid maturation of protein aggregates contribute to bacterial dormancy development and recovery. Bollen et al, Nature Communications, 2025.
Funding
This work was supported by FWO, KU Leuven, and VIB.
Gunnar De Winter
.png)